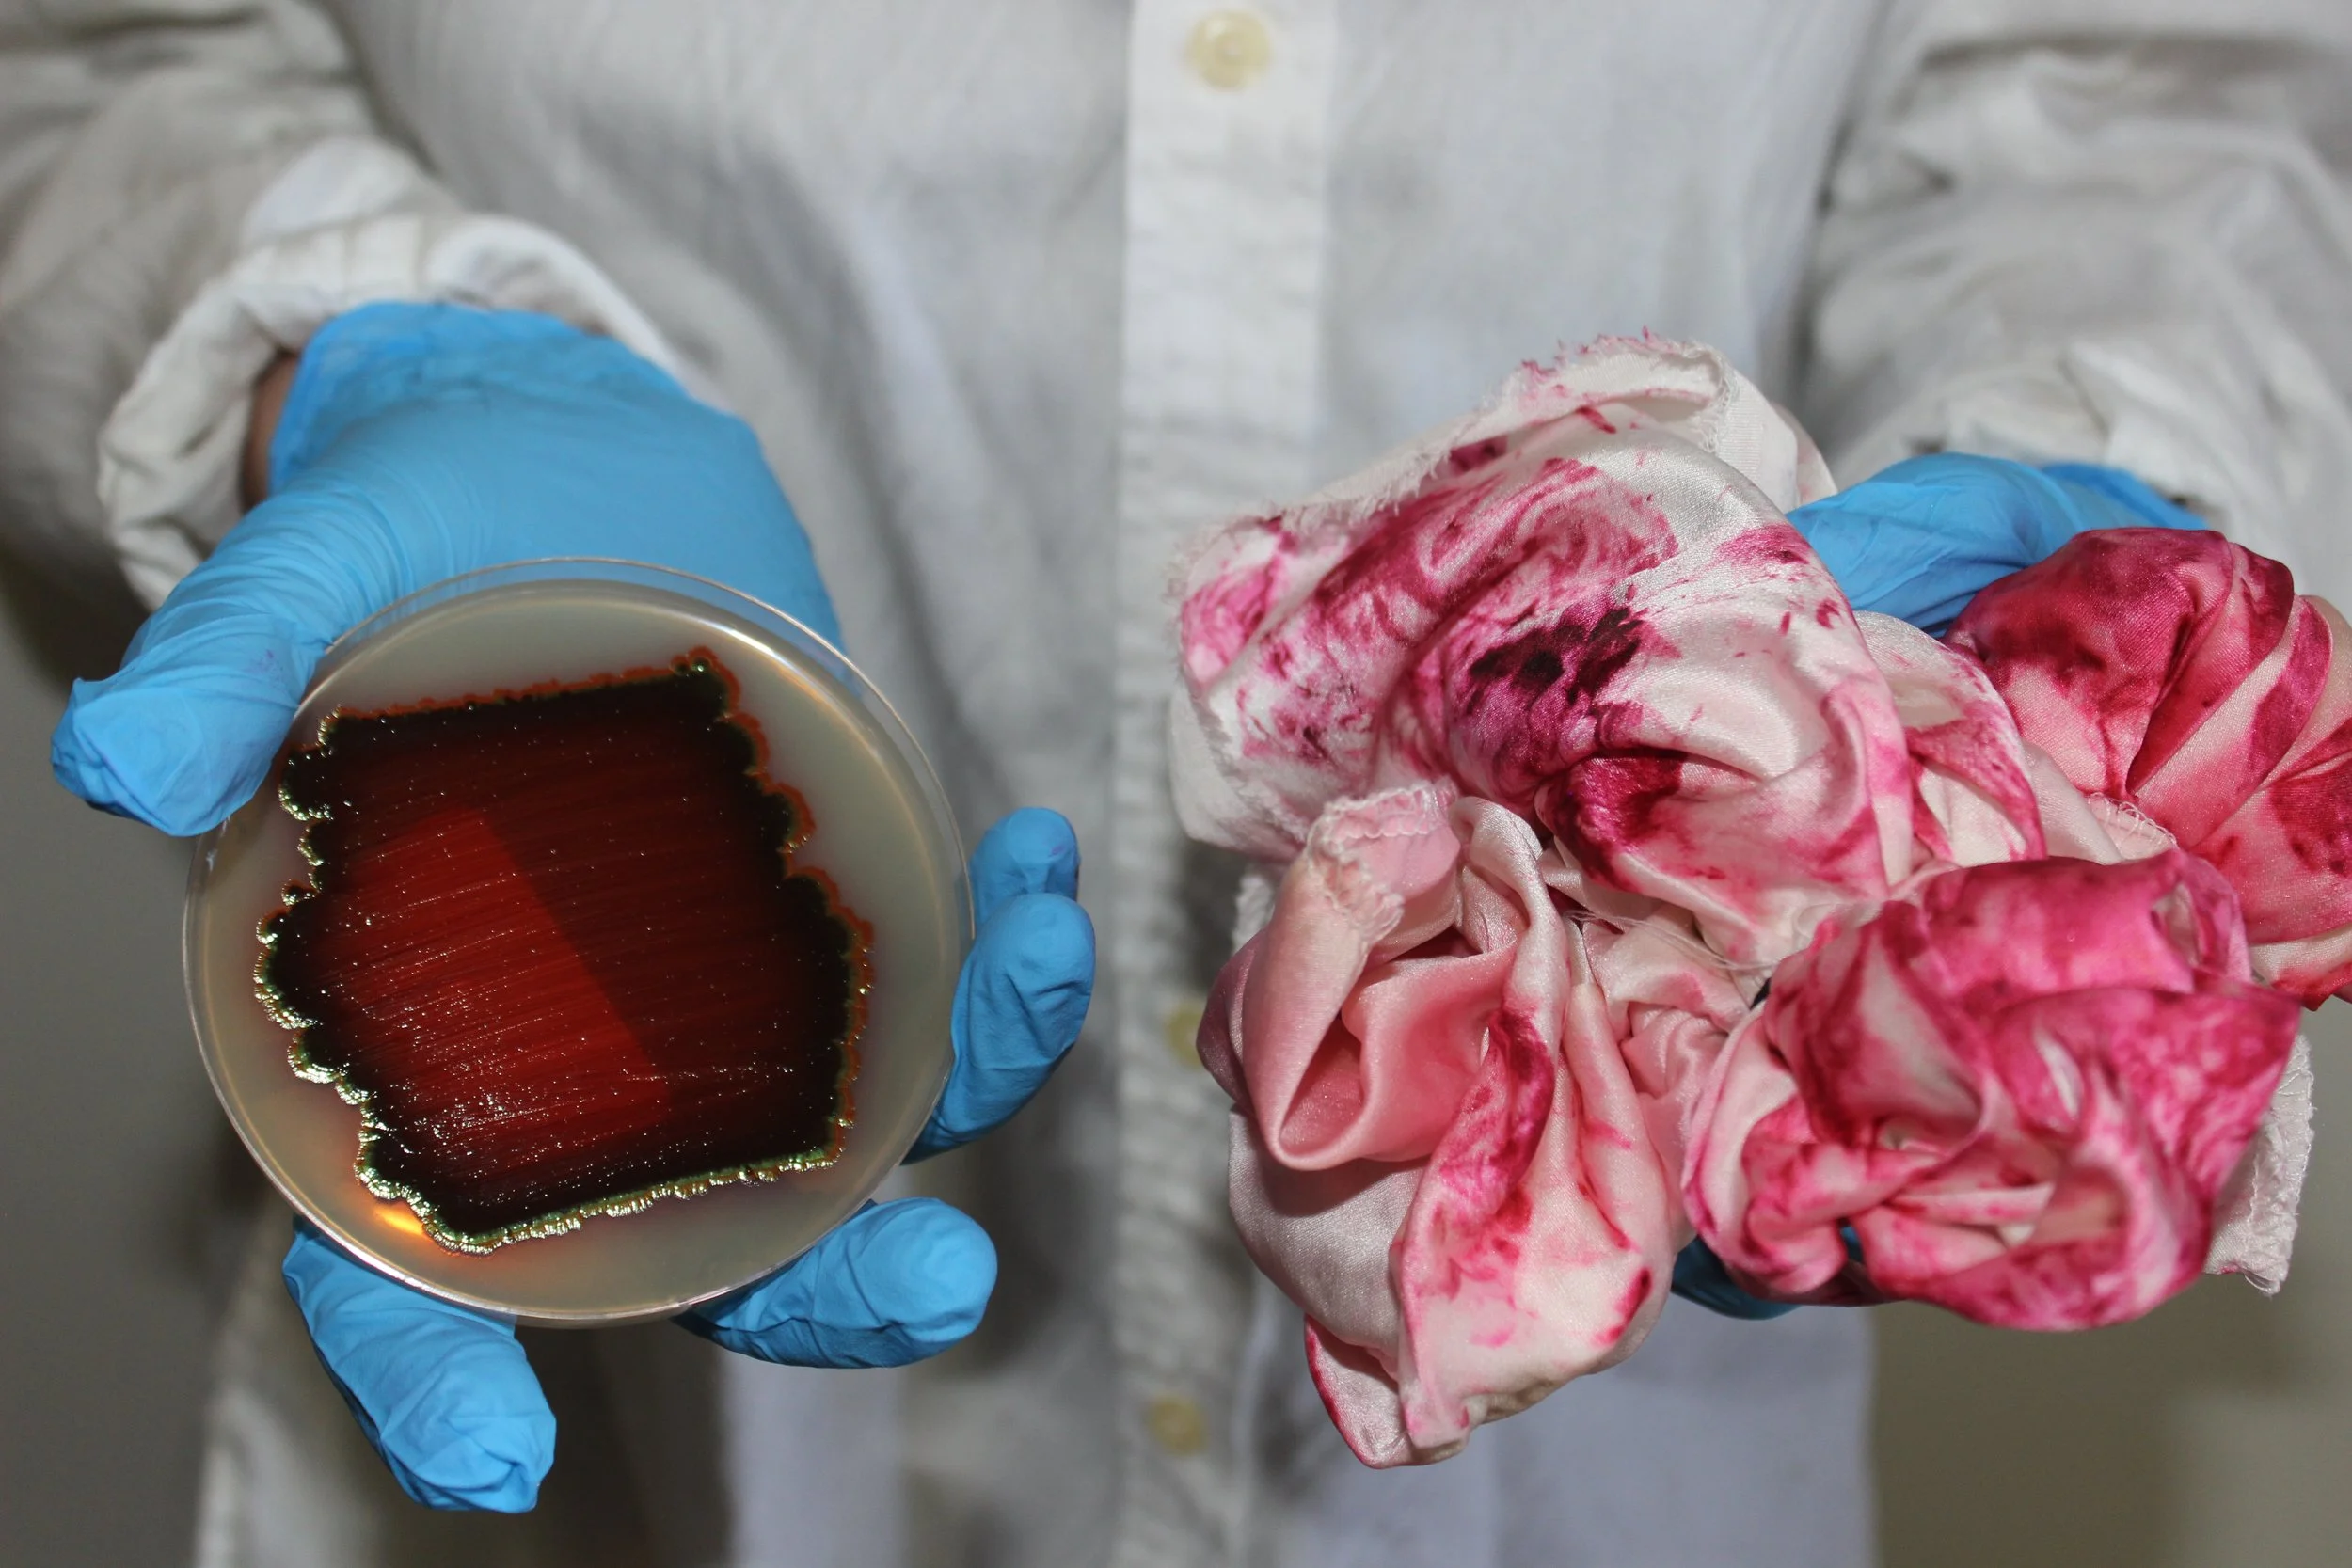

Pioneering the Future of Design & MANUFACTURING
About
Katherine Reeder is an independent designer specializing in manufacturing with next-generation circular materials, Reeder bridges the gap between material innovation and practical production. Through hands-on development with mycelium, bacteria, and other nature-derived materials, she provides crucial feedback to material innovators on real-world manufacturing performance. Her work focuses on transforming these novel materials into market-ready fashion products, driven by her passion for biomaterial innovation.

LET’s WORK TOGETHER
SERVICES OFFERED:

Sample Making & Prototyping

Manufacturing Consultation

Product development
CONTACT
Interested in working together? Fill out some info and I will be in touch shortly.
